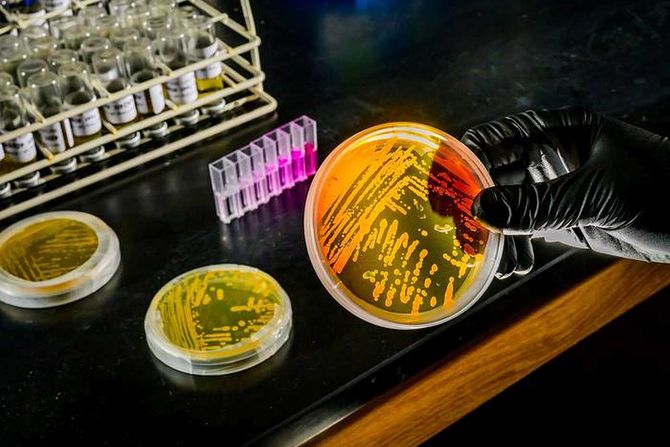

Dubokomorske vode se zagrevaju zbog toplotnih talasa i klimatskih promena, što bi moglo biti problem za osetljivu hemijsku i biološku ravnotežu okeana.
Međutim, nova studija pokazuje da se mikrob Nitrosopumilus maritimus možda već dobro prilagođava toplijim, nutrijentima siromašnim vodama. Istraživači predviđaju da će ove iznenađujuće prilagodljive arheje koje zavise od gvožđa i oksidiraju amonijak igrati važnu ulogu u preoblikovanju okeanske distribucije nutrijenata u promenljivoj klimi.
Nitrosopumilus maritimus i njegovi rođaci čine oko 30% morske mikrobne planktonske populacije i mnogi istraživači se slažu da okeani zavise od ovih mikroba radi hemijskih reakcija koje podržavaju morski život.
Aktivnost oksidiranja amonijaka čini arheje ključnim igračima u kruženju nutrijenata u okeanima. Menjajući oblike azota u morskoj vodi, kontrolišu rast mikrobnog planktona – osnove morskog lanca ishrane – i pomažu u održavanju morskog biodiverziteta.
„Efekti zagrevanja okeana mogu se proširiti na dubine od 1.000 metara ili više“, kažu istraživači sa Univerziteta Ilinois u Urbana-Šampejnu. „Nekad smo mislili da su dublje vode uglavnom izolovane od površinskog zagrevanja, ali sad postaje jasno da zagrevanje dubokog mora može promeniti kako ovo obilje arheja koristi gvožđe – metal od kog uveliko zavise – potencijalno utičući na dostupnost malih količina metala u dubokom okeanu“.
Istraživači su eksperimentalno otkrili da povećanje temperature pod uslovima sa ograničenim gvožđem redukuje potrebe mikroba za gvožđem i povećava fiziološku efikasnost upotrebe gvožđa, što pokazuje da se mikrobi dobro prilagođavaju na stres usled povećanih temperatura i smanjene dostupnosti gvožđa.
„Ove nalaze smo povezali sa globalnim okeanskim biogeohemijskim modeliranjem. Rezultati sugerišu da zajednice arheja u dubokom okeanu mogu održati ili čak poboljšati svoju ulogu u kruženju azota i podržavanju primarne produkcije širom ogromnih regiona sa ograničenim gvožđem u zagrevajućem klimatu“, kažu istraživači.
Ovog leta će istraživačka ekspedicija sastavljena od više od 20 naučnika raditi na potvrđivanju ovih novih eksperimentalnih nalaza u stvarnom svetu, fokusirajući se na interaktivne efekte temperature i ograničenja metala na prirodne populacije arheja.
(Telegraf Nauka/EurekAlert)
Video: Intervju sa Edvardom Fergusonom
Nauka Telegraf zadržava sva prava nad sadržajem. Za preuzimanje sadržaja pogledajte uputstva na stranici Uslovi korišćenja.